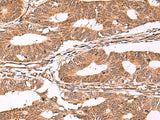
IST1 Polyclonal Antibody Reactivity Rat

IST1 Polyclonal Antibody Reactivity Rat
SKU: E-AB-52046-200
IST1 Polyclonal Antibody Reactivity Rat
| SKU # | E-AB-52046 |
| Reactivity | Human, Mouse |
| Host | Rabbit |
| Applications | IHC |
Product Details
| Isotype | IgG |
| Host | Rabbit |
| Reactivity | Human, Mouse, Rat |
| Applications | IHC |
| Clonality | Polyclonal |
| Immunogen | Synthetic peptide of human IST1 |
| Abbre | IST1 |
| Synonyms | IST1, IST1 homolog, Increased sodium tolerance 1, Increased sodium tolerance 1 homolog, KIAA0174, MAPK activating protein PM28, MGC117220, MGC128433, Putative MAPK-activating protein PM28, hIST1 |
| Swissprot | |
| Cellular Localization | Cytoplasmic vesicle. Localizes to the midbody of dividing cells. |
| Concentration | 1.08 mg/mL |
| Buffer | Phosphate buffered solution, pH 7.4, containing 0.05% stabilizer and 50% glycerol. |
| Purification Method | Antigen affinity purification |
| Research Areas | Cell Biology |
| Conjugation | Unconjugated |
| Storage | Store at -20°C Valid for 12 months. Avoid freeze / thaw cycles. |
| Shipping | The product is shipped with ice pack, upon receipt, store it immediately at the temperature recommended. |
Related Reagents
| Applications | Recommended Dilution |
| IHC | 1:40-1:200 |
Background
This gene encodes a protein with MIT-interacting motifs that interacts with components of endosomal sorting complexes required for transport (ESCRT). ESCRT functions in vesicle budding, such as that which occurs during membrane abscission in cytokinesis. There is a pseudogene for this gene on chromosome 19. Alternatively spliced transcript variants encoding multiple isoforms have been observed for this gene.